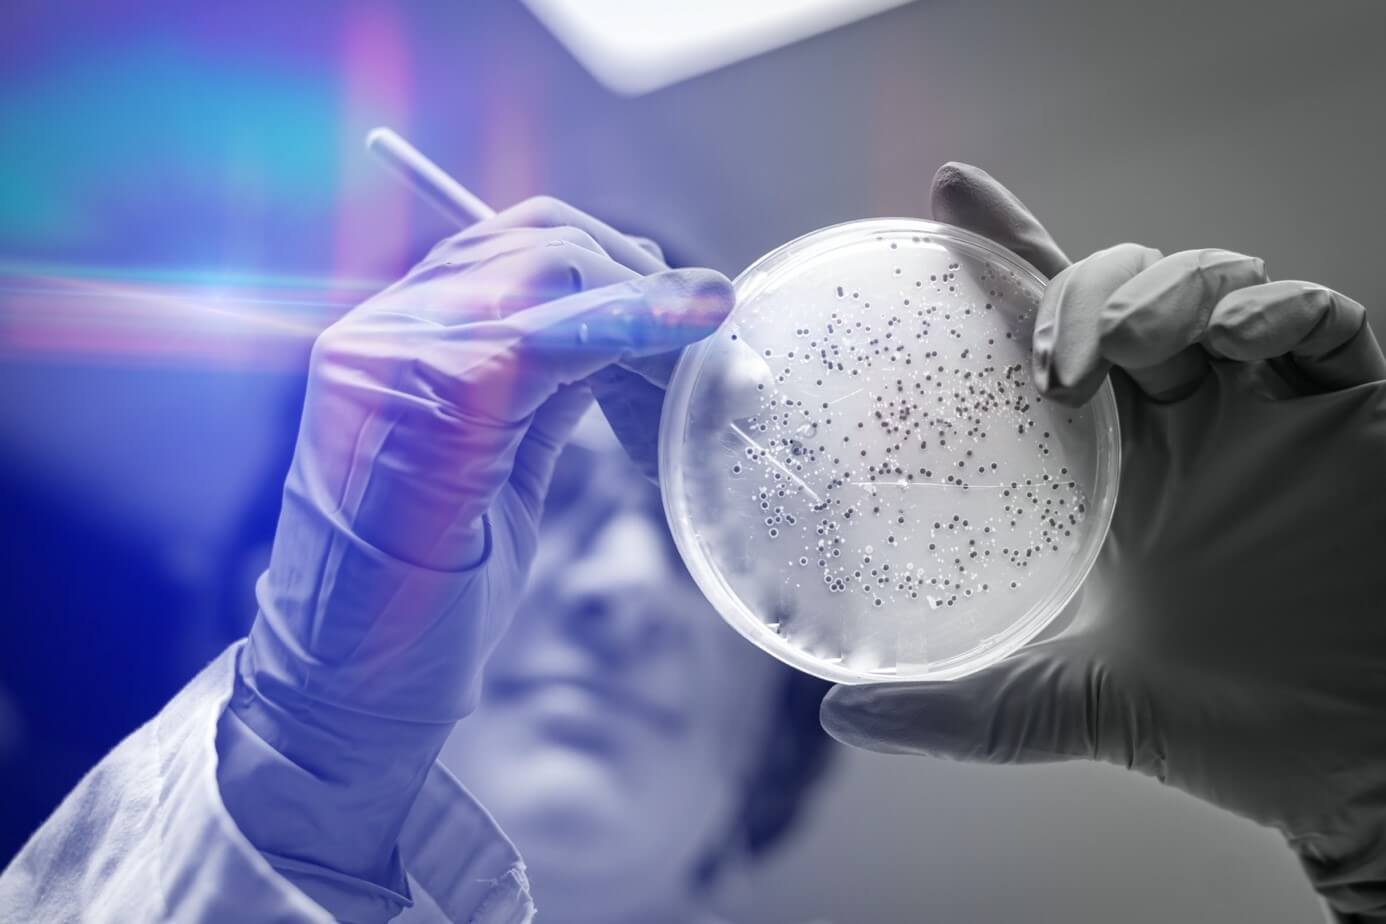

Achetez nos produits en ligne


Comment une dysbiose intestinale perturbe votre système immunitaire
Mis à jour: 10 Mars 2021Lorsque votre microbiote intestinal est perturbé, cela peut augmenter les risques d’infections en favorisant la prolifération d’agents pathogènes nocifs. Ainsi, comprendre son interaction particulière avec le système immunitaire est essentiel dans la prévention des troubles inflammatoires.
La majorité des preuves scientifiques suggèrent que les métabolites et les antigènes du microbiote intestinal peuvent influencer la régulation immunitaire. Par conséquent, une dysbiose pourrait être le facteur environnemental responsable de certains troubles immunitaires et inflammatoires. Il existe de plusieurs preuves qui affirment que la dysbiose avec une perturbation de l'équilibre immunitaire conduisant à plusieurs troubles chroniques non transmissibles (MNT) allant de l'allergie, de l'asthme aux troubles neurodégénératifs. Un faible degré d'inflammation peut également entraîner le développement de conditions similaires.
De nombreuses études corroborent qu’une fois que la communauté microbienne dysbiotique est établie, cela peut affecter considérablement le développement et les activités des cellules immunitaires. Cette perturbation provoque alors une boucle de rétroaction entre le système immunitaire de l’hôte et son microbiote qui se régulent mutuellement.
Dans le contexte d’une dysbiose, la signalisation microbienne au système immunitaire joue un rôle clé. C’est elle qui permet le maintien de l'état dysbiotique intestinal obtenu par au moins 2 phénomènes différents :
L’étroite symbiose entre le microbiote intestinal et la réaction du système immunitaire peut parfois poser problème. Cela peut induire en erreur tout le processus de défenses. C’est le cas lorsque les interactions entre les microbes intestinaux ne s’opèrent pas de manière optimale. Si les messages communiqués par le microbiote intestinal sont mal interprétés, le système immunitaire peut mal réagir en étant trop rapide ou virulent. Cela peut induire une réponse auto-immune contre des éléments inoffensifs et provoquer ainsi le développement de diverses troubles qui ne semblent avoir aucun rapport avec la composition du microbiote intestinal.
Le cas flagrant qui illustre ce problème est l’étude du Caltech sur la sclérose en plaques, une maladie du système nerveux central. Grâce à des expérimentations sur des souris, les chercheurs de l’Institut de technologie de Californie ont démontré que la rapidité avec laquelle la réponse auto-immune attaquait son propre système nerveux pouvait être déterminée par le type de bactéries présentes dans l’intestin.
Cette découverte a ouvert la porte à d’autres études afin de mieux comprendre à quel point un dysfonctionnement du microbiote intestinal pouvait favoriser le développement de troubles. La maladie cœliaque fait actuellement partie de ces recherches. Il s’agit d’une pathologie intestinale auto-immune qui est déclenchée par une réponse immunitaire aux peptides présents dans le gluten alimentaire. Si elle s’accompagne de changements dysbiotiques, aucune signature dysbiotique cohérente n’a été pour l’instant déterminée. Plusieurs recherches ont suggéré que la composition et la fonction du microbiote intestinal pouvaient contribuer au développement de la maladie cœliaque, mais aucune étude n'a été réalisée pour élucider les mécanismes par lesquels la dysbiose pourrait entraîner la susceptibilité de la maladie.
L’influence de la composition de votre microbiote intestinal ne s’arrête pas là. Elle peut dès votre naissance favoriser des problèmes qui pourront se déclencher des années après. En effet, la colonisation microbienne précoce des tissus muqueux durant la petite enfance influence durablement l’hôte. Cela peut être le cas des allergies et de l’asthme. Il a été démontré que des conditions sans germe et une exposition précoce aux antibiotiques peuvent être associées à une sensibilité accrue à ces deux troubles.
Des études menées sur des souris suggèrent que la colonisation néonatale influence l'éducation du système immunitaire. Après plusieurs tests, les scientifiques ont constaté une dysbiose microbienne accompagnée d'une réduction des taux d'acétate fécal chez les nourrissons à risque d'asthme. Ils ont également pu observer une amélioration de l’inflammation des voies respiratoires chez la souris sans germe grâce à la restauration de 4 genres bactériens qui sont généralement en abondance réduites chez les sujets à risque.
Malgré tout, les scientifiques ont encore beaucoup de choses à découvrir quant aux associations de troubles à médiation immunitaire avec la dysbiose. Finalement, ils ont à ce jour encore trop peu de données. Il reste donc très difficile de savoir si la dysbiose est une cause directe de la manifestation d’une altération ou si les changements dans les communautés microbiennes chez les personnes malades sont le résultat d'un changement de l'hôte.